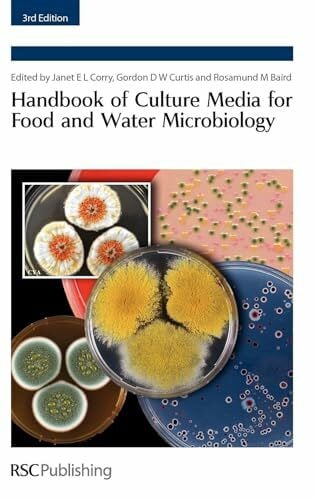
Baird, Rosamund M. Handbook of Culture Media for Food and Water Microbiology

Baird, Rosamund M. Handbook of Culture Media for Food and Water Microbiology
Baird, Rosamund M. Handbook of Culture Media for Food and Water Microbiology ist auf Lager und wird versandt, sobald es wieder verfügbar ist
Verfügbarkeit für Abholungen konnte nicht geladen werden
Lieferung und Versand
Lieferung und Versand
Wir versenden deine Bestellung innerhalb eines Werktages.
• Die Versandkosten werden im Checkout automatisch berechnet – nähere Infos findest Du [hier].
• Nach dem Versand erhältst du eine Sendungsverfolgung per E-Mail, damit du immer weißt, wo sich dein Buch auf der Reise befindet.
• Wir verpacken ressourcenschonend – in bereits verwendeten oder recycelten Kartons, ganz im Sinne unserer nachhaltigen Mission.
Sicher bezahlen – mit Vertrauen und Schutz
Wir verarbeiten alle Zahlungen verschlüsselt und speichern keine Kreditkarteninformationen. So kannst du ganz entspannt und geschützt einkaufen.